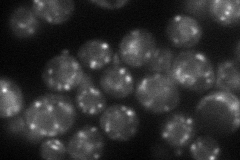
YEL036C
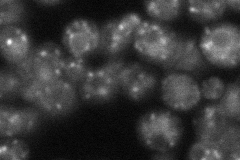
YEL036C
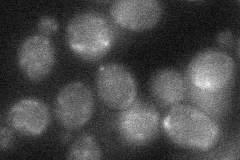
YEL036C
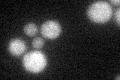
YEL036C

View description
Subunit of the alpha-1,6 mannosyltransferase complex; type II membrane protein; has a role in retention of glycosyltransferases in the Golgi; involved in osmotic sensitivity and resistance to aminonitrophenyl propanediol
Localization:
Intensity:
Fold change:
Significance:
-
C’ GFP library in SD

punctate25.47 -
N' NOP1pr-GFP in SD
punctate60.0382 -
N' TEF2pr-mCherry in SD
punctate38.8033 -
N' NATIVEpr-GFP in SD

punctate26.7033 -
N' TEF2pr-VC and Cyto-VN in SD
below threshold27.0057 -
C’ GFP library in SD+DTT
punctate16.760.65Yes -
C’ GFP library in SD+H2O2

punctate20.80.81No -
C’ GFP library in Starvation Media

punctate18.460.72Yes -
C’ GFP library on the background of Pup2-DaMP

punctate -
C’ GFP library on the background of CCT mutant

punctate21.33880.83756No
